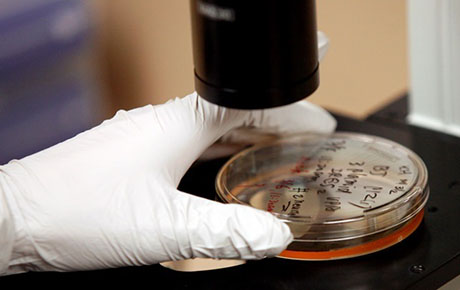
Свежие новости: От гепатитов B и C страдает 325 млн человек - ВОЗ

Общество | 29 Июля, 2018
От гепатитов B и C страдает 325 млн человек - ВОЗ
От вирусных гепатитов B и C страдают 325 млн человек по всему миру, сообщили во Всемирной организация здравоохранения (ВОЗ).
"Вирусные гепатиты B и C представляют собой серьезную проблему для здравоохранения, затрагивающую 325 миллионов человек по всему миру. Они являются базовой причиной рака печени, от которого ежегодно умирает 1,34 миллиона человек", – говорится в сообщении.
Отмечается, что как минимум 60% случаев рака печени связаны с поздним диагностированием и лечением вирусов гепатита В и С.
"Недостаточный охват тестированием и лечением – самый серьезный пробел, который необходимо ликвидировать для достижения к 2030 году глобальных целей по элиминации гепатита", – подчеркнули в ВОЗ.













